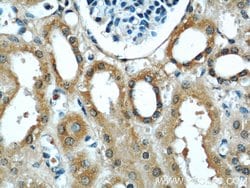
UPF1 Rabbit anti-Human, Mouse, Rat, Polyclonal, Proteintech:Antibodies:Primary

missing translation for 'onlineSavingsMsg'
Learn More
Learn More
UPF1 Rabbit anti-Human, Mouse, Rat, Polyclonal, Proteintech
Rabbit Polyclonal Antibody
121.38€ - 418.21€
Specifications
| Antigen | UPF1 |
|---|---|
| Concentration | 0.33 mg/mL |
| Applications | Immunofluorescence, Immunohistochemistry (Paraffin), Immunocytochemistry, Western Blot, Immunoprecipitation |
| Classification | Polyclonal |
| Conjugate | Unconjugated |
Description
Upf1 was identified as an active component in nonsense-mediated decay (NMD), an mRNA surveillance mechanism in eukaryotic cells that degrades mRNAs containing premature termination codons. Upf1 was found to be an ATP-dependent RNA helicase in the cytoplasm and was later shown to be a component of cytoplasmic P-bodies. Upf1 phosphorylation mediates the repression of translation that accompanies NMD, allowing mRNA accessibility to the NMD machinery. Two other active components of NMD, Upf2 and Upf3, were also identified and described as having perinuclear and nucleocytoplasmic localization, respectively.Specifications
| UPF1 | |
| Immunofluorescence, Immunohistochemistry (Paraffin), Immunocytochemistry, Western Blot, Immunoprecipitation | |
| Unconjugated | |
| Rabbit | |
| Rat, Mouse, Human | |
| Q92900, Q9EPU0 | |
| 19704, 5976, 684558 | |
| UPF1 Fusion Protein Ag16195 | |
| Primary | |
| -20°C | |
| UPF1 |
| 0.33 mg/mL | |
| Polyclonal | |
| Liquid | |
| RUO | |
| PBS with 50% glycerol and 0.02% sodium azide; pH 7.3 | |
| ATP dependent helicase RENT1, HUPF1, KIAA0221, NORF1, pNORF1, RENT1, UPF1 | |
| UPF1 | |
| IgG | |
| Antigen Affinity Chromatography | |
| Antibody |
Spot an opportunity for improvement?Share a Content Correction
Product Content Correction
Your input is important to us. Please complete this form to provide feedback related to the content on this product.
Product Title